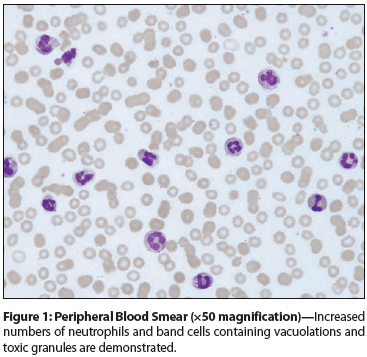

A 76-year-old woman with a history of dementia, hypertension, type 2 diabetes mellitus, and newly diagnosed squamous cell carcinoma of the urinary bladder was referred to Indiana University Medical Center after 3 to 4 weeks of hospitalization at two other hospitals.
Figure 1: Peripheral Blood Smear (×50 magnification)
Figure 2: Bone Marrow Aspirate (×50 magnification)

Table: Leukocytosis Associated With Carcinoma of the Bladder: Results of a Review of the Literaturea

The Case: A 76-year-old woman with a history of dementia, hypertension, type 2 diabetes mellitus, and newly diagnosed squamous cell carcinoma (SCC) of the urinary bladder was referred to Indiana University Medical Center (IUMC) after 3 to 4 weeks of hospitalization at two other hospitals. She had undergone a transurethral resection of bladder tumor (TURBT) before being transferred to IUMC. Review of the histopathologic specimen confirmed a diagnosis of moderately differentiated SCC of the urinary bladder invading the muscularis propria (T2). No angiolymphatic invasion was identified, but extensive necrosis was seen within the tumor. Subsequent staging workup did not show any evidence of metastasis.
At presentation to IUMC, the patient had a leukocyte count of 45,000/μL, with predominant neutrophils (> 90%) and significant band cells (> 5%). Her vital signs were stable except for asymptomatic hypothermia (< 35ºC [95.0ºF]). She was not oriented to time or place, which was consistent with her baseline and due to dementia. A review of other systems and a physical examination were unremarkable.
Infectious workups done at the previous hospitals were only remarkable for uncomplicated urinary tract infections (pan-sensitive Escherichia coli; vancomycin-resistant Enterococcus faecium; and Candida glabrata), all of which were treated appropriately. Because the patient met systemic inflammatory response syndrome (SIRS) criteria at transfer (leukocyte count > 12,000/μL and hypothermia), blood and urine cultures were obtained, and she was started on broad-spectrum intravenous antibiotics. No organism was isolated from culture specimens. CT scans of her head, chest, abdomen, and pelvis did not demonstrate any source of infection. The patient’s condition remained unchanged over the next several days.
The patient continued to have an elevated leukocyte count over 22 days of hospitalization (median, 36,750/μL; range, 16,900–50,200/μL). Peripheral blood smears were consistent with a leukemoid reaction (a large number of neutrophils containing toxic granules and several band cells) (Figure 1). These findings prompted more urine and blood cultures, all of which showed no significant growth. Further hematologic workup, including a BCR-ABL polymerase chain reaction assay, a leukocyte alkaline phosphatase (LAP) test, and bone marrow biopsy and aspiration, were unremarkable (Figure 2). Of note, the bone marrow specimen was also sent for bacterial, fungal, and acid-fast bacilli (AFB) cultures, but did not demonstrate any growth.
The possibility of a paraneoplastic leukocytosis secondary to SCC of the urinary bladder was considered. A serum granulocyte colony-stimulating factor (G-CSF) level was obtained, and was high at 134.1 pg/mL (reference range < 39.1 pg/mL).
Given the patient’s dementia, poor functional status, and locally advanced disease, her family decided not to pursue further treatment. She was subsequently discharged to hospice care.
More than 70,000 new cases of bladder cancer are diagnosed annually in the United States.[1] Bladder cancer is also responsible for more than 15,000 US deaths each year.
Paraneoplastic syndromes are unusual with bladder cancers.[2] Some cases of paraneoplastic leukocytosis have been described with transitional cell carcinomas (TCC) of the bladder, but it is rare with other histologic types.
The Table summarizes clinical features of 35 patients (34 from a literature review plus the new case reported here) who had leukocytosis associated with bladder carcinoma. Twenty-five patients (71.4%) were male. The median age of the patients was 73 years (range, 48–94 years). Twenty-three of these cases were reported from Japan. TCC was the most frequent histology; 19 patients (54.3%) had TCC exclusively and 5 (14.3%) had TCC in combination with another histology. Twenty-three tumors (65.7%) were described as high-grade, grade 3, or poorly differentiated. The maximum reported leukocyte count was recorded for all patients (median, 51,300/μL; range, 20,300–181,800/μL). Serum G-CSF levels were reported in 26 cases. Twenty-five patients had elevated G-CSF levels (median, 131 pg/mL; range, 52–4,928 pg/mL); one patient had normal G-CSF levels but was reported to have paraneoplastic leukocytosis on the basis of positive G-CSF immunostaining of the tumor specimen. Twenty-two patients had G-CSF immunostaining performed on their tumor specimen for confirmation.
Six patients manifested leukocytosis only with recurrence. Nine patients had associated hypercalcemia; six of these had a documented elevated parathyroid hormone-related protein level. In all 24 patients with any description of extent of spread, the tumor had invaded at least the muscularis propria. Nineteen patients survived 12 months or less; the median survival was 7.5 months.
These demographic and histologic features of patients with leukocytosis associated with bladder cancer appear to be similar to those generally observed in bladder cancers.[3] Bladder cancer has a peak incidence in 50- to 70-year-olds and is 3 times more common in males; TCC accounts for more than 90% of cases. However, the proportion of high-grade/poorly differentiated tumors appears to be high in the cases reviewed here. It is interesting to note that the majority of cases were reported from Japan; the incidence of bladder cancer in Japan is similar to that in other developed countries. Specific genetic or environmental factors may be implicated in the etiology, leading to a different tumor biology. In a small cohort of 141 Japanese patients with bladder cancers studied by Mizutani et al, approximately 9% had elevated serum G-CSF levels.[4] These G-CSF levels correlated with the leukocyte counts; the proportion of patients who had leukocytosis with elevated G-CSF levels was, however, not reported.
About 70% of bladder cancers are superficial at the time of diagnosis; only 10% to 20% invade the muscularis propria on recurrence.[3,5] However, at least 24 of 35 patients reported in the literature and reviewed here had involvement of the muscularis propria or deeper tissues at diagnosis; this translated to a shorter survival time. Moreover, the tumor was described as high-grade or poorly differentiated in 23 cases. These findings suggest that patients who have bladder cancer and an elevated G-CSF level may possess more aggressive tumor biology.
Mizutani et al reported that high-grade tumor histology and advanced stage of bladder cancer were associated with elevated G-CSF levels.[4] One might argue that high G-CSF levels are a consequence of advanced disease rather than its cause, and therefore, that paraneoplastic leukocytosis would be more severe with higher tumor burden. However, there is evidence that secretion of G-CSF confers a more aggressive nature to the tumor. An autocrine growth model has been demonstrated in vitro from a cell line obtained from a Japanese patient with TCC. The cell line displayed expression of both G-CSF and G-CSF receptors; cellular proliferation was stimulated by administration of exogenous G-CSF and inhibited by anti–G-CSF antibody. G-CSF receptor expression has been demonstrated in several TCC cell lines; these cell lines display enhanced proliferation when incubated with G-CSF.[6] In another series, G-CSF receptor mRNA was detected in 23% of patients with TCC; the authors raised concerns regarding the use of G-CSF for chemotherapy-induced myelosuppression in such patients and recommended testing for the G-CSF receptor before using G-CSF.[7] Other mechanisms mediated by fibroblast growth factor (FGF) and mononuclear cells have also been suggested for tumors of a more aggressive nature.[8] Bladder cancers with G-CSF and G-CSF receptor expression have also been demonstrated to have higher levels of beta-1 integrin, an adhesion molecule associated with an invasive cancer phenotype.[9]
Paraneoplastic leukocytosis is rare in SCC of the urinary bladder. Bladder cancers with paraneoplastic G-CSF production and leukocytosis appear to have high-grade histology and present as more advanced disease. Several mechanisms could contribute to the more aggressive tumor biology, including stimulation of neoplastic cell proliferation by G-CSF/G-CSF receptor autocrine models, FGF and mononuclear cells, or enhanced beta-1 integrin–mediated invasiveness. The majority of the literature about paraneoplastic leukocytosis in bladder cancer is based on Japanese patients; it is important that similar findings be reported in other populations.
Financial Disclosure:The authors have no significant financial interest or other relationship with the manufacturers of any products or providers of any service mentioned in this article.
1. Siegel R, Naishadham D, Jemal A. Cancer statistics, 2013. CA Cancer J Clin. 2013;63:11-30.
2. Sacco E, Pinto F, Sasso F, et al. Paraneoplastic syndromes in patients with urological malignancies. Urol Int. 2009;83:1-11.
3. Kaufman DS, Shipley WU, Feldman AS. Bladder cancer. Lancet. 2009;374:239-49.
4. Mizutani Y, Okada Y, Terachi T, et al. Serum granulocyte colony-stimulating factor levels in patients with urinary bladder tumour and various urological malignancies. Br J Urol. 1995;76:580-6.
5. Rübben H, Lutzeyer W, Fischer N, et al. Natural history and treatment of low and high risk superficial bladder tumors. J Urol. 1988;139:283-5.
6. Ohigashi T, Tachibana M, Tazaki H, Nakamura N. Bladder cancer cells express functional receptors for granulocyte-colony stimulating factor. J Urol. 1992;147:283-6.
7. Tachibana M, Miyakawa A, Uchida A, et al. Granulocyte colony-stimulating factor receptor expression on human transitional cell carcinoma of the bladder. Br J Cancer. 1997;75:1489-96.
8. Ohmi C, Matsuyama H, Tei Y, et al. Granulocyte colony-stimulating factor may promote proliferation of human bladder cancer cells mediated by basic fibroblast growth factor. Scand J Urol Nephrol. 2003;37:286-91.
9. Chakraborty A, White SM, Lerner SP. Granulocyte colony-stimulating factor receptor signals for beta1-integrin expression and adhesion in bladder cancer. Urology. 2004;63:177-83.
10. Block NL, Whitmore WF, Jr. Leukemoid reaction, thrombocytosis and hypercalcemia associated with bladder cancer. J Urol. 1973;110:660-3.
11. Dukes JW, Tierney LM, Jr. Paraneoplastic leukemoid reaction as marker for transitional cell carcinoma recurrence. Urology. 2009;73:928.e17-9.
12. Georgilis K, Athanassiades P. Leukocytosis associated with and localized bladder cancer: resolution with radiation therapy. J Urol. 1999;161:1567.
13. Hirasawa K, Kitamura T, Oka T, Matsushita H. Bladder tumor producing granulocyte colony-stimulating factor and parathyroid hormone related protein. J Urol. 2002;167:2130.
14. Ito N, Matsuda T, Kakehi Y, et al. Bladder cancer producing granulocyte colony-stimulating factor. N Engl J Med. 1990;323:1709-10.
15. Ito T, Shimamura K, Shoji K, et al. Urinary bladder carcinoma producing granulocyte colony stimulating factor (G-CSF): a case report with immunohistochemistry. Virchows Arch A Pathol Anat Histopathol. 1993;422:487-90.
16. Kamai T, Arai G, Takagi K. Granulocyte colony-stimulating factor and parathyroid hormone related protein producing bladder cancer. J Urol. 1999;161:1565-6.
17. McRae SN, Gilbert R, Deamant FD, Reese JH. Poorly differentiated carcinoma of bladder producing granulocyte colony-stimulating factor and parathyroid hormone related protein. J Urol. 2001;165:527-8.
18. Miller JI, Sarver RG, Drach GW. Leukemoid reaction: a rare paraneoplastic syndrome associated with advanced bladder carcinoma. Urology. 1994;44:444-6.
19. Mongha R, Narayan S, Das R, Kundu A. Fever and leukemoid reaction: a rare paraneoplastic manifestation of bladder carcinoma. Indian J Cancer. 2008;45:131-2.
20. Narayana AS, Kelly DG, Duff FA. Leukaemoid reaction in a case of leiomyosarcoma of the bladder. Postgrad Med J. 1977;53:766-8.
21. Nemoto R, Nakamura I, Oshika Y, Nakamura M. Transitional cell carcinoma of the bladder producing granulocyte colony-stimulating factor: a case report of molecular diagnosis. Br J Urol. 1996;78:653-4.
22. Nishimura K, Higashino M, Hara T, Oka T. Bladder cancer producing granulocyte colony-stimulating factor: a case report. Int J Urol. 1996;3:152-4.
23. Otani N, Kumamoto Y, Tsukamoto T, et al. Bladder carcinoma producing granulocyte colony-stimulating factor. Urol Int. 1994;52:115-7.
24. Sato K, Terada K, Sugiyama T, et al. Granulocyte colony-stimulating factor produced by bladder carcinoma of a patient with leukemoid reaction did not affect proliferation of the tumor cells. J Urol. 1994;151:1687-90.
25. Satoh H, Abe Y, Katoh Y, et al. Bladder carcinoma producing granulocyte colony-stimulating factor: a case report. J Urol. 1993;149:843-5.
26. Stav K, Leibovici D, Siegel YI, Lindner A. Leukemoid reaction associated with transitional cell carcinoma. Isr Med Assoc J. 2002;4:223-4.
27. Turalic H, Deamant FD, Reese JH. Paraneoplastic production of granulocyte colony-stimulating factor in a bladder carcinoma. Scand J Urol Nephrol. 2006;40:429-32.
28. Tachibana M, Miyakawa A, Tazaki H, et al. Autocrine growth of transitional cell carcinoma of the bladder induced by granulocyte-colony stimulating factor. Cancer Res. 1995;55:3438-43.
29. Ueno M, Ban S, Ohigashi T, et al. Simultaneous production of granulocyte colony-stimulating factor and parathyroid hormone-related protein in bladder cancer. Int J Urol. 2000;7:72-5.
30. Vaidyanathan S, Mansour P, Ueno M, et al. Problems in early diagnosis of bladder cancer in a spinal cord injury patient: report of a case of simultaneous production of granulocyte colony stimulating factor and parathyroid hormone-related protein by squamous cell carcinoma of urinary bladder. BMC Urol. 2002;2:8.
31. Otomo R, Yamashiro S, Nishizawa O, et al. A case of bladder carcinoma representing leukemoid reaction. Nihon Hinyokika Gakkai Zasshi. 1993;84:382-5.
32. Kajio K, Hasegawa Y, Ihara K, et al. Granulocyte colony-stimulating factor producing undifferentiated carcinoma of urinary bladder: a case report. Nihon Hinyokika Gakkai Zasshi. 2000;91:679-82.
33. Akiyama A, Ohkubo Y, Hokoishi F, et al. Bladder carcinoma producing granulocyte colony stimulating factor (G-CSF). A case report. Nihon Hinyokika Gakkai Zasshi. 1994;85:1135-8.
34. Yoshino T, Yoneda K. Urinary bladder cancer producing granulocyte-colony stimulating factor: a case report and review of the literature. Hinyokika Kiyo. 2008;54:775-8.
35. Tsuchiya F, Ikeda I, Kanda F, Fukuoka H. A case of bladder tumor producing granulocyte-colony stimulation factor and parathyroid hormone-related protein. Hinyokika Kiyo. 2001;47:873-6.
36. Shimizu N, Miyatake R, Esa A. Squamous cell carcinoma of bladder producing granulocyte colony-stimulating factor (G-CSF): a case report. Hinyokika Kiyo. 2005;51:121-4.
37. Kawanishi H, Aoyama T, Yoshida T, et al. Bladder carcinoma producing granulocyte colony-stimulating factor (G-CSF): a case report. Hinyokika Kiyo. 2001;47:429-32.
38. Iwata T, Araki H, Kushima R, et al. A case of bladder tumor producing granulocyte colony-stimulating factor. Hinyokika Kiyo. 1999;45:847-50.
39. Ito S, Iwai Y, Fujii T, et al. Two cases of bladder tumor producing granulocyte colony stimulating factor. Hinyokika Kiyo. 1999;45:57-60.
40. Ishida K, Yuhara K, Kanimoto Y. A case of bladder tumor producing granulocyte colony-stimulating factor. Hinyokika Kiyo. 2004;50:253-6.
41. Asano T, Morimoto S, Kitami Y, et al. Bladder cancer producing granulocyte colony-stimulating factor (G-CSF): a case report. Hinyokika Kiyo. 2002;48:495-8.
42. Alamé T, De Weweire A, Gris P, et al. Leukemoid reaction and hypercalcemia in carcinoma of the bladder. Rev Med Brux. 1990;11:59-62.